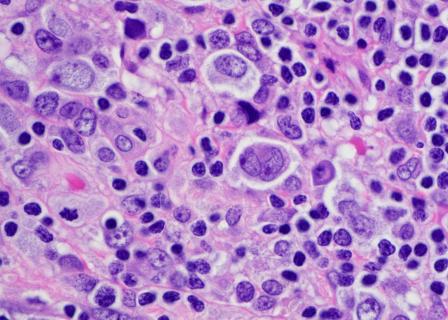

Ashish07 Startups
Artificial Intelligence In Digital Genome Market
Sent 946 days ago
by Ashish07
Electric And Acoustic Guitar Strings Market
Sent 952 days ago
by Ashish07